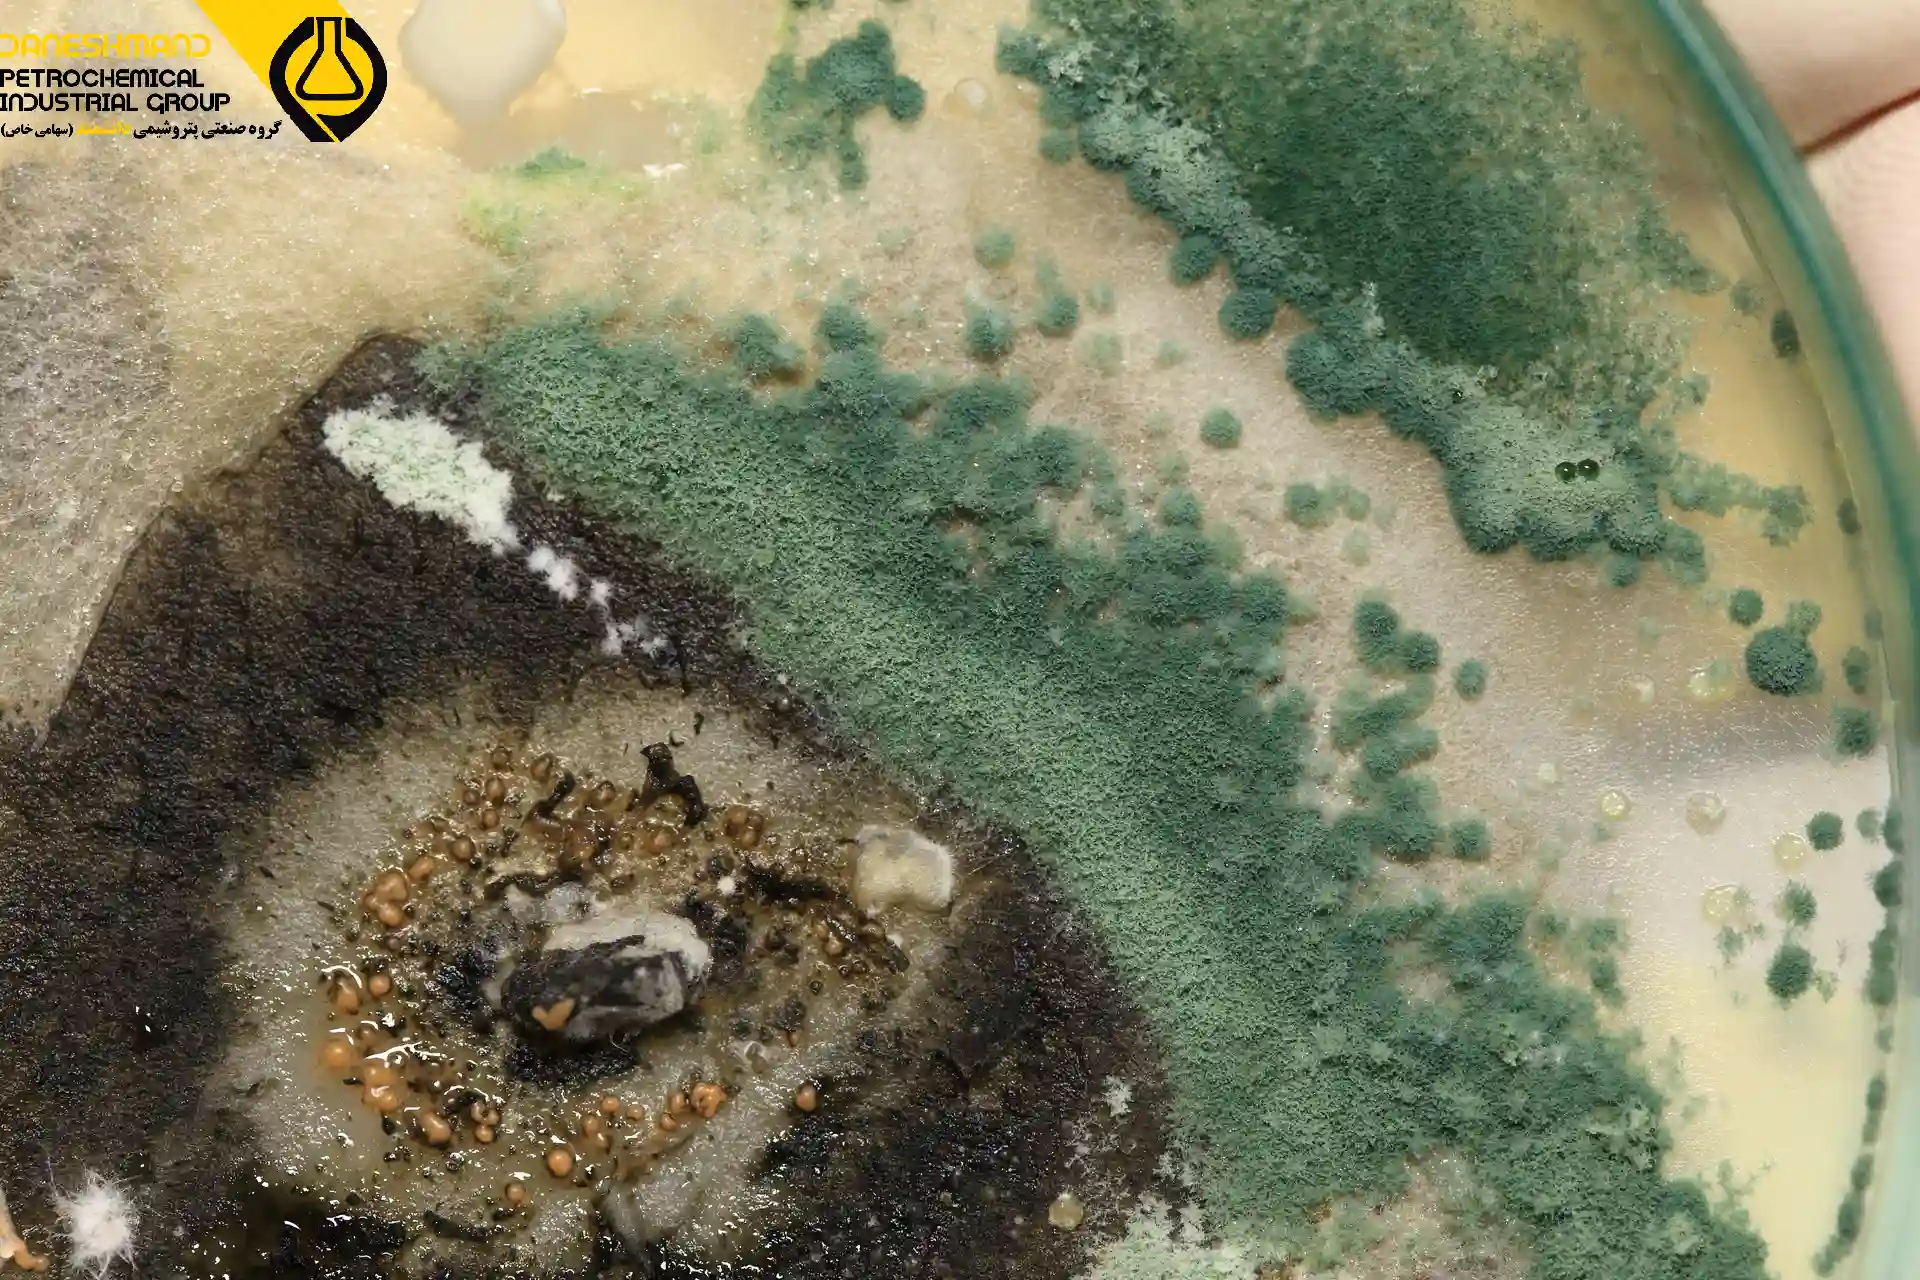
قبل از خرید ضد کپک صنعتی، این 3 نکته حیاتی رو بدون!

قبل از خرید ضد کپک صنعتی، این 3 نکته حیاتی رو بدون!
در بسیاری از صنایع شیمیایی و تولیدی، رشد کپک و قارچ میتواند کیفیت نهایی محصول را کاهش دهد. این مشکل در صنایع رنگ، چسب، رزین و تکمیل پارچهها بسیار رایج است.
ضد کپک صنعتی (Industrial Anti-Mold Agent) یک افزودنی تخصصی است که برای مهار رشد قارچ و کپک در محیطهای مرطوب یا گرم طراحی شده و حتی در غلظتهای پایین عملکرد عالی دارد.
با این حال، همه ضد کپکها یکسان نیستند و انتخاب نادرست میتواند باعث کاهش اثرگذاری یا واکنشهای ناخواسته در محصول شود. پیش از خرید، باید به نکات کلیدی توجه کنید تا بهترین عملکرد را دریافت کنید.
در این مقاله، تعریف، کاربرد، مزایا و نکات خرید ضد کپک صنعتی را بررسی میکنیم تا انتخابی هوشمندانه داشته باشید.
~~~~~~~~~~~~~~~~~~~~~~~~~~~~~~
🔴امکان ارسال این محصول به سراسر کشور در کمتر از ۷ روز، با قیمت مناسب و بدون واسطه فراهم است🔴
🔸 برای دریافت اطلاعات بیشتر و استعلام قیمت، لطفاً در تماس باشید 🔸
~~~~~~~~~~~~~~~~~~~~~~~~~~~~~~
تعریف واضح و دقیق ضد کپک صنعتی
ضد کپک صنعتی نوعی ماده شیمیایی است که با هدف مهار رشد قارچ، کپک و مخمر طراحی میشود. این مواد معمولاً از گروه ایزوتیازولینونها (Isothiazolinones)، فنولها، کارباماتها یا ترکیبات نیترو تشکیل شدهاند. مکانیسم اثر آنها به این صورت است که با تخریب غشای سلولی قارچها و اختلال در متابولیسم آنها، مانع از تنفس و تکثیر میشوند.
این مواد به دو دسته کلی تقسیم میشوند:
ضد کپک درونسیستمی (In-Can Preservative):
برای محافظت از رنگها، چسبها، امولسیونها، و خمیرها در زمان انبارداری استفاده میشود.
این نوع از کپکزدگی درون ظرف جلوگیری میکند و مانع از بوی بد، تغییر رنگ و گازدار شدن محصول میشود.ضد کپک سطحی (Film Preservative):
پس از اعمال رنگ یا پوشش روی سطح، از رشد قارچ روی فیلم خشکشده جلوگیری میکند. این نوع ضد کپک مخصوص مناطقی با رطوبت بالا و تهویه ضعیف است.
ضد کپک صنعتی بسته به ترکیب شیمیایی خود میتواند پایهآبی، روغنی یا محلول در الکل باشد و معمولاً در دمای معمولی پایداری بالایی دارد.

کاربرد ضد کپک صنعتی در صنایع مختلف
کاربرد ضد کپک صنعتی گسترده و حیاتی است. تقریباً هر صنعتی که با رطوبت، مواد آلی یا ترکیبات پلیمری سروکار دارد، به نوعی از این ماده نیاز دارد. در ادامه به مهمترین صنایع مصرفکننده اشاره میکنیم:
1. صنعت رنگ و پوشش
رنگهای پایه آبی محیطی ایدهآل برای رشد قارچها هستند. کپک میتواند باعث تغییر رنگ، ایجاد بوی ناخوشایند و از بین رفتن چسبندگی فیلم رنگ شود. ضد کپک صنعتی با جلوگیری از رشد میکروارگانیسمها، پایداری محصول را افزایش میدهد و عمر مفید رنگ را چندین برابر میکند.
2. صنعت چسب و لاتکس
چسبهای امولسیونی و لاتکسها بهدلیل وجود ترکیبات آلی و آب فراوان، بهشدت مستعد کپکزدگی هستند. استفاده از ضد کپک صنعتی موجب ثبات فیزیکی، افزایش ماندگاری و جلوگیری از فساد بیولوژیکی میشود.
3. صنعت نساجی
در فرآیند تکمیل پارچه و انبارداری، رطوبت و گرما شرایط ایدهآلی برای رشد کپک ایجاد میکند. افزودن ضد کپک صنعتی در مرحلهی فینیشینگ از ایجاد لکههای قارچی، تغییر رنگ پارچه و بوی نامطبوع جلوگیری میکند.
4. صنعت چوب، MDF و مبلمان
چوب طبیعی منبع مواد قندی و سلولزی است که بهراحتی مورد حمله کپک قرار میگیرد. ضد کپک صنعتی با ایجاد پوشش محافظ روی سطح چوب، از پوسیدگی، تغییر رنگ و از بین رفتن زیبایی چوب جلوگیری میکند.
5. صنایع آب و سیستمهای خنککننده
در برج های خنک کننده و سیستمهای بسته، قارچها و کپکها میتوانند بهسرعت گسترش یابند و باعث انسداد مسیر جریان آب و کاهش راندمان سیستم شوند. افزودن ضد کپک صنعتی در کنار بایوسایدها، از این مشکل جلوگیری میکند.
6. صنایع چاپ و بستهبندی
در مرکبهای چاپ پایه آبی، رشد کپک میتواند باعث تغییر رنگ، افت کیفیت چاپ و ایجاد بوی ناخوشایند شود. استفاده از ضد کپک صنعتی کیفیت چاپ را ثابت نگه میدارد.

مزایا و ویژگیهای ضد کپک صنعتی
ضد کپک صنعتی تنها یک افزودنی ساده نیست، بلکه یکی از عوامل کلیدی در حفظ پایداری و کیفیت محصولات نهایی است. برخی از مهمترین ویژگیها و مزایای آن عبارتاند از:
جلوگیری مؤثر از رشد قارچ، کپک، مخمر و جلبک
افزایش طول عمر نگهداری محصولات تا چندین ماه
جلوگیری از تغییر رنگ، بوی بد و افت کیفیت در حین انبارداری
حفظ خواص فیزیکی و شیمیایی رنگها و چسبها
سازگاری بالا با بیشتر رزینها، امولسیونها و مواد افزودنی
عملکرد مؤثر در بازهی وسیع pH (از 4 تا 9)
مقاومت بالا در برابر حرارت، نور و رطوبت
اثر پایدار حتی پس از خشک شدن سطح
فرمولهای جدید بدون فلزات سنگین و فرمالدهید
ایمن برای کارگران و بدون بوی تند شیمیایی
ضد کپکهای مدرن معمولاً با سایر مواد ضد میکروبی مانند بایوسایدها و ضد باکتریها ترکیب میشوند تا حفاظت کاملتری در برابر عوامل میکروبی ایجاد کنند.
مقایسه ضد کپک صنعتی با مواد مشابه
در بازار مواد شیمیایی صنعتی، گاهی ضد کپک با بایوساید، ضد قارچ یا نگهدارنده (Preservative) اشتباه گرفته میشود. هرچند این مواد عملکرد مشابهی دارند، اما از نظر کاربرد و دوام اثر تفاوت زیادی بین آنها وجود دارد.
| ویژگی | ضد کپک صنعتی | بایوساید صنعتی | ضد قارچ معمولی |
|---|---|---|---|
| هدف اصلی | جلوگیری از کپک و قارچ | کنترل انواع باکتری و جلبک | جلوگیری از قارچ سطحی |
| مدت ماندگاری اثر | طولانی (تا 12 ماه) | متوسط | کوتاه |
| کاربرد اصلی | رنگ، چسب، نساجی، چوب | تصفیه آب، شویندهها | مصارف خانگی |
| پایداری در pH بالا | بالا | متوسط | ضعیف |
| سمیت زیستمحیطی | پایین (در فرمولهای جدید) | متغیر | معمولاً بالا |
| سازگاری با افزودنیها | عالی | متوسط | محدود |
نتیجه این مقایسه واضح است:
اگر هدف شما جلوگیری بلندمدت از رشد قارچ و کپک در محیطهای صنعتی است، ضد کپک صنعتی بهترین گزینه است، بهویژه اگر از برند معتبر و فرمولاسیون استاندارد استفاده کنید.
پرسش و پاسخهای رایج درباره ضد کپک صنعتی
1. آیا ضد کپک صنعتی برای محیط زیست مضر است؟
در گذشته، برخی ترکیبات حاوی فلزات سنگین مانند جیوه یا قلع بودند، اما امروزه شرکتهایی نظیر پتروشیمی دانشمند از فرمولهای جدیدی استفاده میکنند که فاقد فلزات سمی بوده و با استانداردهای زیستمحیطی (EU REACH, EPA) مطابقت دارند.
2. مقدار مصرف ضد کپک صنعتی چقدر است؟
دوز مصرف معمولاً بین 0.05 تا 0.3 درصد وزنی نسبت به کل فرمولاسیون است. برای کاربردهای سطحی ممکن است تا 0.5 درصد نیز افزایش یابد. انتخاب مقدار دقیق باید با توجه به نوع محصول و محیط نگهداری انجام شود.
3. آیا میتوان ضد کپک صنعتی را با سایر مواد شیمیایی ترکیب کرد؟
بله، این مواد معمولاً با دترجنتها، ضد کفها، بایوسایدها و تثبیتکنندههای pH سازگار هستند. بااینحال، برای جلوگیری از ناپایداری احتمالی، تست سازگاری آزمایشگاهی قبل از تولید انبوه توصیه میشود.
4. ماندگاری خود ضد کپک صنعتی چقدر است؟
در صورتیکه در دمای اتاق (زیر ۳۰ درجه سانتیگراد) و محیط خشک نگهداری شود، بین ۱۲ تا ۱۸ ماه ماندگاری دارد.
5. آیا ضد کپک صنعتی قابل استفاده در محصولات غذایی است؟
خیر. این محصولات صرفاً برای مصارف صنعتی طراحی شدهاند و نباید در تماس مستقیم با مواد غذایی یا نوشیدنیها قرار گیرند.
جمعبندی
ضد کپک صنعتی یک افزودنی کلیدی برای افزایش ماندگاری، پایداری و کیفیت محصولات صنعتی است. در صنایعی که رطوبت، گرما و مواد آلی حضور دارند، این ماده نقش حیاتی در حفظ کیفیت نهایی محصول ایفا میکند.
پیش از خرید هر نوع ضد کپک، حتماً این سه نکته حیاتی را در نظر بگیرید:
نوع سیستم و محیط کاربرد: آیا محصول شما پایه آبی است یا حلالی؟ نوع سیستم در انتخاب ضد کپک مؤثر است.
سازگاری با سایر افزودنیها: برخی ضد کپکها با دترجنتها یا مواد قلیایی ناسازگارند، پس بررسی سازگاری الزامی است.
کیفیت و برند تولیدکننده: خرید از شرکتهای معتبر مانند پتروشیمی دانشمند تضمینکنندهی کیفیت و خلوص ترکیبات است.
هلدینگ پتروشیمی خاتم (KPC) با تکیه بر دانش فنی و تجربه در تأمین افزودنیهای صنعتی، انواع ضد کپک صنعتی باکیفیت بالا را متناسب با نیاز صنایع رنگ، چسب، نساجی و چوب عرضه میکند.
برای دریافت مشاوره فنی، نمونه محصول و استعلام قیمت، همین حالا با کارشناسان پتروشیمی دانشمند تماس بگیرید.
~~~~~~~~~~~~~~~~~~~~~~~~~~~~~~
🔴امکان ارسال این محصول به سراسر کشور در کمتر از ۷ روز، با قیمت مناسب و بدون واسطه فراهم است🔴
🔸 برای دریافت اطلاعات بیشتر و استعلام قیمت، لطفاً در تماس باشید 🔸
~~~~~~~~~~~~~~~~~~~~~~~~~~~~~~